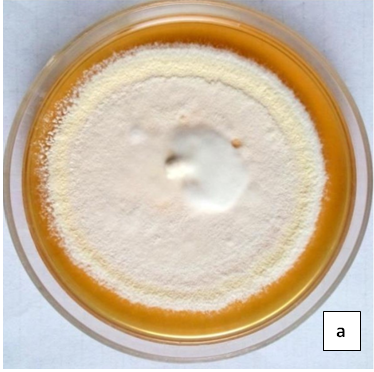

Int J Pharm Pharm Sci, Vol 14, Issue 5, 36-41Original Article
A STUDY OF PATTERN OF ONYCHOMYCOSIS IN A TERTIARY CARE HOSPITAL OF CENTRAL INDIA
GAURAV SAXENA1 , KALPANA SADAWARTE2 , MOHIT KULMI3 , ABHISHEK MEHTA4*
1Department of Microbiology, Government Medical College, Ratlam (MP), 2Department of Microbiology, People’s College of Medical Sciences and Research Centre, Bhopal (MP), 3Department of Pharmacology, Government Medical College, Ratlam (MP), 4Department of Microbiology, Government Medical College, Datia (MP)
Email: abhishekmehta623@gmail.com
Received: 17 Feb 2022, Revised and Accepted: 11 Apr 2022
ABSTRACT
Objective: This study was undertaken to study the clinico-mycological profile of clinically suspected cases of onychomycosis in the region.
Methods: In this cross-sectional study, 65non-repetitive, clinically diagnosed cases of onychomycosis visiting Dermatology, Venereology and Leprosy OPD of People’s Hospital, Bhopal were included. Nail clippings and scraping beneath the nails were taken from the affected sites. Collected specimens were subjected to standard mycological procedures.
Results: Males were more affected than females. The male to female ratio was 1.4:1. Distal and lateral subungual onychomycosis (DLSO) was the commonest clinical pattern. Out of the total 35 fungal culture isolates, dermatophytes (71.43%) were the most common. Among dermatophytes, Trichophyton rubrum and among non-dermatophytes, Candida spp. was the most common isolate.
Conclusion: Dermatophytes were the most common aetiological agent of onychomycosis in our study with Trichophyton rubrum as the most common isolate. This study also reveals the fact that nowadays, non, dermatophytes are increasingly isolated from cases of onychomycosis.
Keywords: Onychomycosis, Dermatophytes, KOH wet mount, Fungal culture
© 2022 The Authors. Published by Innovare Academic Sciences Pvt Ltd. This is an open-access article under the CC BY license (https://creativecommons.org/licenses/by/4.0/)
DOI: https://dx.doi.org/10.22159/ijpps.2022v14i5.44465. Journal homepage: https://innovareacademics.in/journals/index.php/ijpps.
INTRODUCTION
Onychomycosis is a fungal infection of the nails and can be caused by dermatophytes, yeasts, or non-dermatophytes. Dermatophytes are considered the most common etiologic agents of onychomycosis and infection caused by them is referred to as Tinea ungium [1]. In India, it mainly affects the low socio-economic sections of the population [2].
The prevalence of onychomycosis across the world was found to be around 3-18 % in different studies [3-7]. It is one of the most common nail diseases and accounts for 20-50% of all nail diseases [1, 3].
Depending upon the morphology of nails during the infection, different clinical patterns of onychomycosis have been described, namely distal and lateral subungual, white superficial, proximal subungual, and total dystrophic onychomycosis (fig. 1)
Onychomycosis affects the male population more frequently and the most common clinical pattern is distal subungual onychomycosis. Toenails are affected more commonly than fingernails [3].
The clinical presentation of onychomycosis mimics many nail diseases such as traumatic onycholysis, nail psoriasis, onychogryphosis, and Lichen Planus making clinical diagnosis difficult and, therefore, laboratory confirmation is necessary. Also, laboratory confirmation is necessary as treatment depends on the fungus species involved whether dermatophyte, yeast or a non-dermatophytic mould [8].
Onychomycosis requires targeted and several months of treatment, as the growth of nails, is very slow, especially in the elderly. Failure to start treatment at the appropriate time may lead to permanent damage to the nail plate. Therefore early institution of antifungal agents is required. Confirmation of an etiological agent by laboratory diagnosis is often time-consuming and therefore starting empirical treatment based on prevalence studies is required till diagnosis is confirmed.
As there is a paucity of such studies in this part of Central India, we have undertaken the study to determine the clinico-mycological profile of suspected cases of onychomycosis in the region.

Fig. 1: Different clinical presentations of Onychomycosis
MATERIALS AND METHODS
This cross-sectional study was undertaken after obtaining clearance from Institutional Ethics Committee, People’s College of Medical Sciences and Research center, Bhopal (PCMS/OD/2013/3808) and after taking written informed consent from the study subjects.
Study population: Clinically diagnosed cases of onychomycosis visiting Dermatology, Venereology and Leprosy OPD of People’s Hospital, Bhopal.
Study period: November 2013-October 2015.
Place of study: Department of Microbiology, PCMS and RC, Bhopal.
Inclusion criteria: -Patients of all age groups and both sex are included in the study.
Exclusion criteria: -Bacterial isolates were excluded. Patients already on antifungals were excluded from the study.
Study type: -Hospital-based, cross-sectional study.
Sample size: -Non-repetitive 65 suspected cases of onychomycosis.
Specimen collection and processing
The affected nail was wiped with 70% ethanol. Then nail clippings and scraping beneath the nails were taken. Samples were collected in clean black paper packets. Collected specimens were subjected to standard mycological procedures.
Direct microscopic examination
KOH wet mount–This was prepared by placing a portion of each sample collected on a glass slide. Then 1-2 drops of 20% or 40% KOH were added and kept for 1-2 h. The slide was then screened for the presence of fungal hyphae.
Fungal culture
The other portion of the collected sample was inoculated onto three test tube slants in duplicate on Sabouraud’s dextrose agar (SDA) with chloramphenicol (0.005%), Sabouraud’s dextrose agar (SDA) with chloramphenicol (0.005%), and cycloheximide (0.05%), and Dermatophyte test medium (DTM). SDA with chloramphenicol and SDA with chloramphenicol and cycloheximide were incubated at 25 °C and 37 °C for up to 4 w and observed periodically for growth. If there was no growth even after 4 w of incubation, it was reported as negative. Dermatophyte test medium (DTM) was incubated at 25 °C and 37 °C for ten days and was observed for color change.
Identification of isolates
Fungal isolates were identified on the basis of distinctive colony characteristics, microscopy features through Lactophenol cotton’s blue (LCB) tease mount, slide culture, urease test, and hair perforation test [1, 9] (fig. 1-10).

Fig. 2: KOH mount of nail specimen

Fig. 3: DTM agar showing growth

Fig. 4a: Growth of trichophyton rubrum on SDA slant

Fig. 4b: LCB mount
Fig. 5a: Growth of Trichophyton mentagrophytes on SDA plate

Fig. 5b: LCB mount

Fig. 6a: Growth of Epidermophyton flocossum on SDA slant

Fig. 6b: LCB mount

Fig. 7a: Growth of Trichophyton tonsurans on SDA plate

Fig. 7b: LCB mount

Fig. 8a: Growth of Alternaria spp. on SDA slants

Fig. 8b: LCB mounts

Fig. 9a: Growth of Curvularia spp.

Fig. 9b: LCB mounts

Fig. 10a: Growth of Aspergillus niger

Fig. 10b: LCB mount
RESULTS
In this study of 65 suspected cases of onychomycosis, patients were distributed between the age ranges of 5-69 y. The mean age of the study group was 36.32 y. Males were more affected than females contributing to 58.46% of total cases. The male to female ratio was 1.4:1. The age group of 31-40 y was most commonly affected with 26 cases (40%) followed by the 41-50 y age group with 14 cases (21.54%) (table 1).
In our study, onychomycosis was most common in agricultural workers (46.15% cases) followed by housewives (23.08%) (table 2)
In our study, distal and lateral subungual onychomycosis (DLSO) was the commonest clinical pattern (63.08%) followed by proximal subungual onychomycosis (21.54%), total dystrophic onychomycosis (13.85%), and Superficial white onychomycosis (1.54%). The toenails were more frequently involved (55.38%) followed by fingernails (29.23%). Both toenails and fingernails were found to be involved in 15.38% of cases (table 3).
Out of 65 clinically suspected cases of onychomycosis, in 45 cases (67.69%) we were able to detect fungi either by direct microscopy and/or culture. In 33cases (50.77%) both microscopy and culture were positive. 9cases (13.85%) were positive only by microscopy but culture turned out to be negative. In 2 cases (3.08%) culture was positive but microscopy was negative. In 21 cases (32.31%) both microscopy and culture were negative (table 4).
Considering fungal culture as the gold standard, direct microscopy (KOH) findings were evaluated. The sensitivity of direct Microscopy (KOH) was found to be 94.29% and the specificity turned out to be 70% (table 5).
Out of the total of 35 fungal isolates, the dermatophytes were the most common (71.43%). Amongst dermatophytes, there were 12 (48%) isolates of Trichophyton rubrum followed by 09 (36%) isolates of Trichophyton mentagrophyte, 03(12%) of Trichophyton tonsurans, and 01(4%) of Epidermophyton floccosum. Non-dermatophyte isolates were 10(28.57%) of which 4(40%) were Candida spp. and 2 isolates each of Alternaria spp., Curvularia spp., and Aspergillus niger (table 6).
Table 1: Age-wise distribution of dermatophytes
| Age in years | Male | Female | Number of cases |
| <10 | 01(100%) | 00(00%) | 01 (1.54%) |
| 11-20 | 02(66.67%) | 01(33.33%) | 03(4.62%) |
| 21-30 | 06(60%) | 04(40%) | 10(15.38%) |
| 31-40 | 15(57.69%) | 11(42.31%) | 26(40%) |
| 41-50 | 09(64.29%) | 05(35.71%) | 14(21.54%) |
| 51-60 | 04(44.44%) | 05(55.56%) | 09(13.85%) |
| 61-70 | 01(50%) | 01(50%) | 02(3.08%) |
| Total | 38(58.46%) | 27(41.54%) | 65(100%) |
| M: F=1.4:1 |
Table 2: Occupation details of the study population
| Occupation | Number | % |
| Agricultural worker | 30 | 46.15 |
| Housewife | 15 | 23.08 |
| Students | 07 | 10.77 |
| Office workers | 06 | 9.23 |
| Others | 07 | 10.77 |
| Total | 65 | 100 |
Table 3: The clinical pattern of onychomycosis
| Clinical pattern | Fingernails | Toenails | Both | Total (%) |
| DLSO | 13 | 21 | 07 | 41(63.08) |
| PSO | 04 | 08 | 02 | 14(21.54) |
| SWO | - | 01 | - | 01(1.54) |
| TDO | 02 | 06 | 01 | 09(13.85) |
| Total | 19(29.23%) | 36 (55.38%) | 10 (15.38%) | 65 (100) |
DLSO-Distal and lateral subungual onychomycosis, PSO-Proximal subungual onychomycosis, SWO-Superficial white onychomycosis, TDO–Total Dystrophic onychomycosis
Table 4: KOH and culture findings
| KOH and/or culture+ve | KOH and culture+ve | KOH+ve culture-ve | KOH-ve culture+ve | KOH and culture-ve | |
| Number of cases | 45 | 33 | 09 | 02 | 21 |
| Percentage | 67.69% | 50.77% | 13.85% | 3.08% | 32.31% |
Table 5: Correlation of direct microscopy (KOH) findings with culture
| Culture positive | Culture negative | Total | |
| KOH Positive | 33 | 09 | 42 |
| KOH Negative | 02 | 21 | 23 |
| Total | 35 | 30 | 65 |
| Sensitivity = 94.29%, Specificity = 70%, p value<0.00001 |
Table 6: Culture isolates in the study population
| Fungal isolate (n=35) |
| Dermatophytes (n=25, 71.43%) |
| Trichophyton rubrum |
| Trichophyton mentagrophyte |
| Trichophyton tonsurans |
| Epidermophyton floccosum |
| Total |
DISCUSSION
In our study, 65 clinically suspected cases of onychomycosis visiting the Dermatology, Venereology and Leprosyoutpatient department of People’s Hospital, Bhopal, were studied. In this study, males (58.46%) were more affected than females, the ratio being 1.4:1. These findings are comparable with the other similar studies by Adhikari L et al., Vinod S, Grover S whereas Jesudanam TM et al. have reported a slightly higher prevalence in females. Males are probably more affected due to their frequent indulgence in outdoor work, thereby increasing chances of exposure [10-13].
The age group of 31-40 y was most commonly affected with 26 cases (40%) followed by the age group of 41-50 y with 14 cases (21.54%) which was found similar to studies done by Vinod S, Grover S1and Veer P et al. [11, 12, 14].
In our study, onychomycosis was most common in agricultural workers (46.15%) followed by housewives (23.08%), which was comparable to the study conducted by Niranjan HP et al. [15]. This may be due to increased chances of occupation-related trauma in agricultural workers and the involvement of housewives in household wet work.
In our study, distal and lateral subungual onychomycosis (DLSO) was the commonest clinical pattern (63.08%) and the toenails were more frequently involved (55.38%) than fingernails. Similar findings were reported by Beena et al. and Lone B et al. [16, 17].
In our study diagnostic utility of KOH mount for laboratory diagnosis of onychomycosis was found to be highly significant with a p-value of<0.00001 when compared to the gold standard i.e. culture.
In our study, most of the fungal isolates (71.43%) turned out to be dermatophytes, with Trichophyton rubrum (48%) as the most common isolate, followed by Trichophyton mentagrophyte (36%). These findings were similar to studies done by Veer P et al. and Niranjan HP et al. [14, 15].
Among non-dermatophytes, Candida spp. (40%) was the most common isolate, followed by 2 isolates (20%) each of Alternaria spp., Curvularia spp., and Aspergillus niger. Vijaya D et al. and Gupta M et al. [18, 19] also reported Candida spp. as the most common non-dermatophyte isolate, while Veer P et al. [14] reported Aspergillus spp. as the most common non-dermatophyte isolate.
CONCLUSION
In our study, distal and lateral subungual onychomycosis (DLSO) was the commonest clinical presentation. Dermatophytes were the most common aetiological agent of onychomycosis in our study and Trichophyton rubrum was the most common isolate. This study also reveals the fact that nowadays, non-dermatophytes are increasingly isolated from cases of onychomycosis.
LIMITATIONS OF THE STUDY
Our study is a hospital-based study therefore clinico-mycological profile may vary from the general population. Many of the patients in the general population may not seek medical advice. There is a great need for a carefully conducted population-based prevalence study.
FUNDING
Nil
AUTHORS CONTRIBUTIONS
Concept, design, and defining intellectual content were attributed to Dr. G. Saxena. Literature search and data acquisition was done by Dr. G. Saxena and Dr. K. Sadawarte. Data analysis and interpretation was done by Dr. M. Kulmi and Dr. A. Mehta. The manuscript was prepared by Dr. G. Saxena and Dr. K. Sadawarte. Manuscript Editing and review were done by Dr. M. Kulmi and Dr. A. Mehta. All authors read and approved the final version of the manuscript.
CONFLICT OF INTERESTS
The Authors declare no conflict of interest.
REFERENCES
Chander J. Textbook of medical mycology. 3rd ed. New Delhi: Mehta Publishers; 2009.
Jain N, Meenakshi Sharma M. Topical application of Eugenia caryophyllus oil against ringworm infection of human beings. Asian J Pharm Clin Res. 2019;12(7):153-7. doi: 10.22159/ajpcr.2019.v12i7.32068.
Sigurgeirsson B, Baran R. The prevalence of onychomycosis in the global population: a literature study. J Eur Acad Dermatol Venereol. 2014;28(11):1480-91. doi: 10.1111/jdv.12323, PMID 24283696.
Gupta AK, Simpson FC. Medical devices for the treatment of onychomycosis. Dermatol Ther. 2012;25(6):574-81. doi: 10.1111/j.1529-8019.2012.01519.x, PMID 23210756.
Shemer A. Update: medical treatment of onychomycosis. Dermatol Ther. 2012;25(6):582-93. doi: 10.1111/j.1529-8019.2012.01551.x, PMID 23210757.
Relloso S, Arechavala A, Guelfand L, Maldonado I, Walker L, Agorio I, Reyes S, Giusiano G, Rojas F, Flores V, Capece P, Posse G, Nicola F, Tutzer S, Bianchi M. Onychomycosis: multicentre epidemiological, clinical and mycological study. Rev Iberoam Micol. 2012;29(3):157-63. doi: 10.1016/j.riam.2011.11.003, PMID 22198612.
Nazar JR, Gerosa PE, Diaz OA. Onychomycoses: epidemiology, causative agents and assessment of diagnostic laboratory methods. Rev Argent Microbiol. 2012;44(1):21-5. doi: 10.1590/S0325-75412012000100005, PMID 22610293.
Piraccini BM, Alessandrini A. Onychomycosis: a review. J Fungi (Basel). 2015;1(1):30-43. doi: 10.3390/jof1010030, PMID 29376897.
Devrari JC, Saxena V, Pai V. A mycological study of clinical samples from suspected mycoses in a tertiary care hospital. Asian J Pharm Clin Res. 2018;11(4):267-70. doi: 10.22159/ajpcr.2018.v11i4.24127.
Adhikari L, Das Gupta AD, Pal R, Singh TS. Clinico-etiologic correlates of onychomycosis in sikkim. Indian J Pathol Microbiol. 2009;52(2):194-7. doi: 10.4103/0377-4929.48915, PMID 19332910.
Vinod S, Grover S, Dash K, Singh G. A clinico-mycological evaluation of onychomycosis. Indian J Dermatol Venereol Leprol. 2000;66(5):238-40. PMID 20877087.
Grover S. Clinico mycological evaluation of onychomycosis at Banglore and Jorhat. Indian J Dermatol Venerol Leprol. 2003;69:284-6.
Jesudanam TM, Rao GR, Lakshmi DJ, Kumari GR. Onychomycosis: a significant medical problem. Indian J Dermatol Venereol Leprol. 2002;68(6):326-9. PMID 17656990.
Veer P, Patwardhan NS, Damle AS. Study of onychomycosis: prevailing fungi and pattern of infection. Indian J Med Microbiol. 2007;25(1):53-6. doi: 10.4103/0255-0857.31063, PMID 17377354.
HPN, NP, BP. Study of onychomycosis at a tertiary care hospital in south India. JEMDS. 2012;1(5):823-9. doi: 10.14260/jemds/132.
Beena SS, Bhavana MV, Babu PRS. Onychomycosis: prevalence and its etiology in a tertiary care hospital, South India. Int J Health Sci Res. 2013;3(10):81-5.
Lone R. A study on clinico-mycological profile, aetiological agents and diagnosis of onychomycosis at a government medical college hospital in Kashmir. J Clin Diagn Res. 2013;7(9):1983-5. doi: 10.7860/JCDR/2013/5969.3378.
Vijaya D, Anandkumar BH, Geetha SH. Study of onychomycosis. Indian J Dermatol Venereol Leprol. 2004;70(3):185-6. PMID 17642607.
Gupta M, Sharma NL, Kanga AK, Mahajan VK, Tegta GR. Onychomycosis: clinico-mycologic study of 130 patients from Himachal Pradesh, India. Indian J Dermatol Venereol Leprol. 2007;73(6):389-92. doi: 10.4103/0378-6323.37055, PMID 18032856.